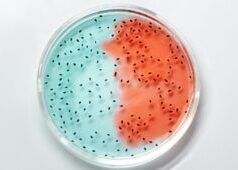
CARPHA celebra la settimana globale di sensibilizzazione sulla resistenza antimicrobica (AMR): evidenzia i progressi regionali nella lotta contro la resistenza antimicrobica

Sabato 15 novembre 2025 14:56
Guarda le notizie dei testimoni oculari, il primo avviso meteorologico e la programmazione originale.
RALEIGH, Carolina del Nord (WTVD) — La polizia di Raleigh afferma che almeno una persona è morta in un incidente sulla I-440 vicino a Capital Boulevard.
Le corsie interne in direzione est e ovest sono state chiuse mentre le autorità indagavano.
Gli automobilisti sono invitati a cercare percorsi alternativi.
Copyright © 2025 WTVD-TV. Tutti i diritti riservati.